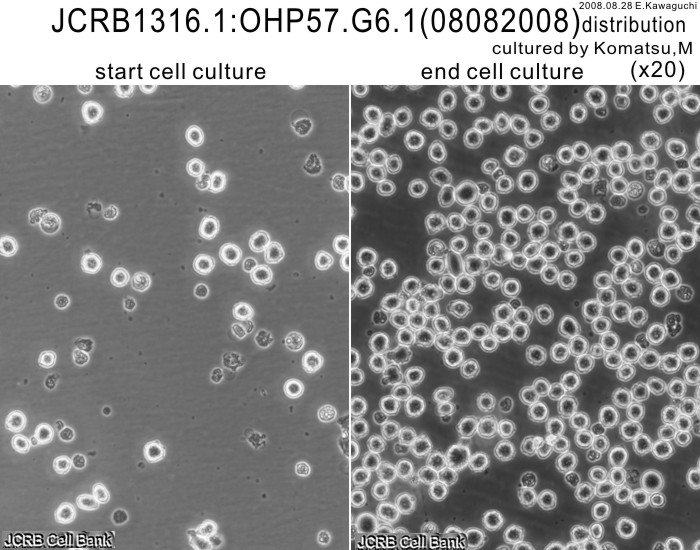

JCRB1316.1 OHP57.G6.1
Cell information
Cell type:general cells (View Pricing Information)
| JCRB No. | JCRB1316.1 | Cell Name | OHP57.G6.1 |
|---|---|---|---|
| Profile | Mouse hybridoma cell line producing monoclonal antibody against 17alpha-hydroxyprogesterone. | Other Name | |
| Animal | mouse | Strain | |
| Genus | hybridoma | Species | |
| Sex | Age | ||
| Identity | not done | Tissue for Primary Cancer | antibody-producing hybridoma |
| Case history | Metastasis | No | |
| Tissue Metastasized | Genetics | ||
| Life Span | infinite | Crisis PDL | |
| Morphology | lymphocyte-like | Character | Producing IgG k. |
| Classify | hybridoma | Established by | Sawada, J. |
| Registered by | Sawada, J. | Regulation for Distribution | |
| Comment | Year | 2007 | |
| Medium | RPMI1640 medium with 10% fetal bovine serum. | Methods for Passages | dilition |
| Cell Number on Passage | split 1/5 (1/2 - 1/10) | Race | |
| CO2 Conc. | 5% | Tissue Sampling | |
| Tissue Type | producing Mab 17alpha-hydroxyprogesterone. |
| Detection of virus genome fragment by Real-time PCR | |||||||||
|---|---|---|---|---|---|---|---|---|---|
| Detected DNA Virus | not tested | Detected RNA Virus | not tested | ||||||
| Reference | |
|---|---|
| Pubmed id:1922102 | Molecular characterization of monoclonal anti-steroid antibodies: primary structures of the variable regions of seven antibodies specific for 17 alpha-hydroxyprogesterone or 11-deoxycortisol and their pH-reactivity profiles. Sawada J,Mizusawa S,Terao T,Naito M,Kurosawa Y Mol Immunol. 1991 Oct;28(10):1063-72 |
| Pubmed id:3312820 | Production and characterization of monoclonal antibodies to 17 alpha-hydroxyprogesterone. Sawada J,Terao T,Itoh S,Maeda M,Tsuji A,Hosoda H,Nambara T J Steroid Biochem. 1987 Oct;28(4):405-10 |
| Images |
|---|
![]() ![]() ![]() ![]() ![]() ![]() ![]() ![]() ![]() ![]() |
LOT Information
Viability/Growth rate/Cell number are represented as actual values measured at lot presentation in JCRB, but are not guaranteed values. Additionally, the doubling time is a rough value measured during passages.| Cell No. | JCRB1316.1 | Cell Name | OHP57.G6.1 |
|---|---|---|---|
| LOT No. | 08082008 | Lot Specification | distribution |
| Medium | RPMI1640 medium with 10% heat inactivated fetal bovine serum (Intergen RB52305) | Temperature | 37 C |
| Cell Density at Seeding | 3.0x10^4 cells/ml | Methods for Passages | 1/5 dilution,(1/2-1/10) |
| Doubling Time | NT | Cell Number in Vial (cells/1ml) | 1.9x10^6 |
| Viability at cell freezing (%) | 89.8 | Antibiotics Used | free |
| Passage Number | p3* | PDL | NT |
| Sterility: MYCOPLASMA | - | Sterility: BACTERIA | - |
| Sterility: FUNGI | - | Isozyme Analysis | NT |
| Chromosome Mode | NT | Chromosome Information | NT |
| Surface Antigen | NT | DNA Profile (STR) | |
| Adhesion | No | Exoteric Gene | NT |
| Medium for Freezing | Cell Banker BLC-1(Nihon Zenyaku Industries) | CO2 Conc. | 5 % |
| Viability immediately after thawing (%) | Additional information |
| Images |
|---|
![]() ![]() ![]() ![]() |